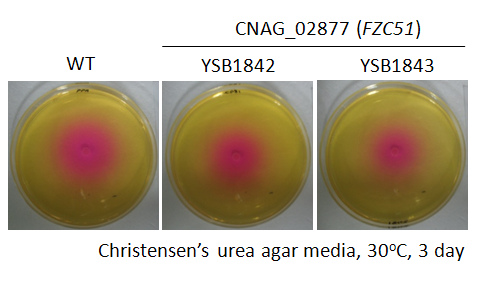

Detailed Locus Information for CNAG_02877T0
| Species | Cryptococcus neoformans var. grubii H99 | |||||||||
|---|---|---|---|---|---|---|---|---|---|---|
| Gene Annotation | hypothetical protein | |||||||||
| Gene Name | FZC51 | |||||||||
| TF Family Name | C2H2 zinc finger (Classification based on Fungal Transcription Factor DB) | |||||||||
| KEGG Linkout | KEGG::CNC04900 |
|||||||||
| Genome Browser | JBrowse link goes here. Sequence information also available from JBrowse. | |||||||||
| Functional Annotation |
|
|||||||||
Expression Data
| Notation | Condition | Normalized Raw Expression |
|---|---|---|
| A | YPD 30°C, concentration: 2x 10^8 cells/ml | 43,709 |
| B | YPD 30°C, concentration: 5x10^7 cells/ml | 20,516 |
| C | YPD 30°C, fluconazole treatment, concentration: 5x10^7 cells/ml | 23,361 |
| D | YPD 30°C, SDS 0.01% treatment, concentration: 5x10^7 cells/ml | 12,317 |
| E | YPD 37°C, concentration: 5x10^7 cells/ml | 8,120 |
| F | YP+galactose 30°C, concentration: 2x10^8 cells/ml | 31,625 |
Gene Disruption Strategy

| Primer Name | Primer Description | Sequence |
|---|---|---|
| L1 | 5' flanking region primer 1 | GTTTACCATTTCACCGCC |
| L2 | 5' flanking region primer 2 | TCACTGGCCGTCGTTTTACTGATGAGGATACATTCGGAG |
| PO | Southern blot probe primer | CAAGTTCCTTTGCCTACACC |
| R1 | 3' flanking region primer 1 | CATGGTCATAGCTGTTTCCTGGGCTTCAACAATCACCATTC |
| R2 | 3' flanking region primer 2 | ACGAAAAGCGGATAGCAG |
| SO | diagnostic screening primer, pairing with B79 | AGCCTTATTATGACCAACCC |
Phenotype Assays
| Growth | |
|---|---|
 |
|
| Mating Data | |
 |
|
| Virulence Factor Production | |
| Capsule | Urease |
 |
|
| Melanin | |
 |
|
| Stress Response and Adaptation | |
| Osmotic Stress | |
 |
|
| Oxidative Stress | Heavy Metal Stress |
 |
 |
| Cell Wall Stress | |
 | |
| Antifungal Drug Susceptibility | |
 |
|
| Virulence Data by the Insect Host Model (Galleria mellonella) | |
 |
|
| Lung Infectivity Data by the Signature-tag Mutagenesis-based Murine Host Model | |
 |
|